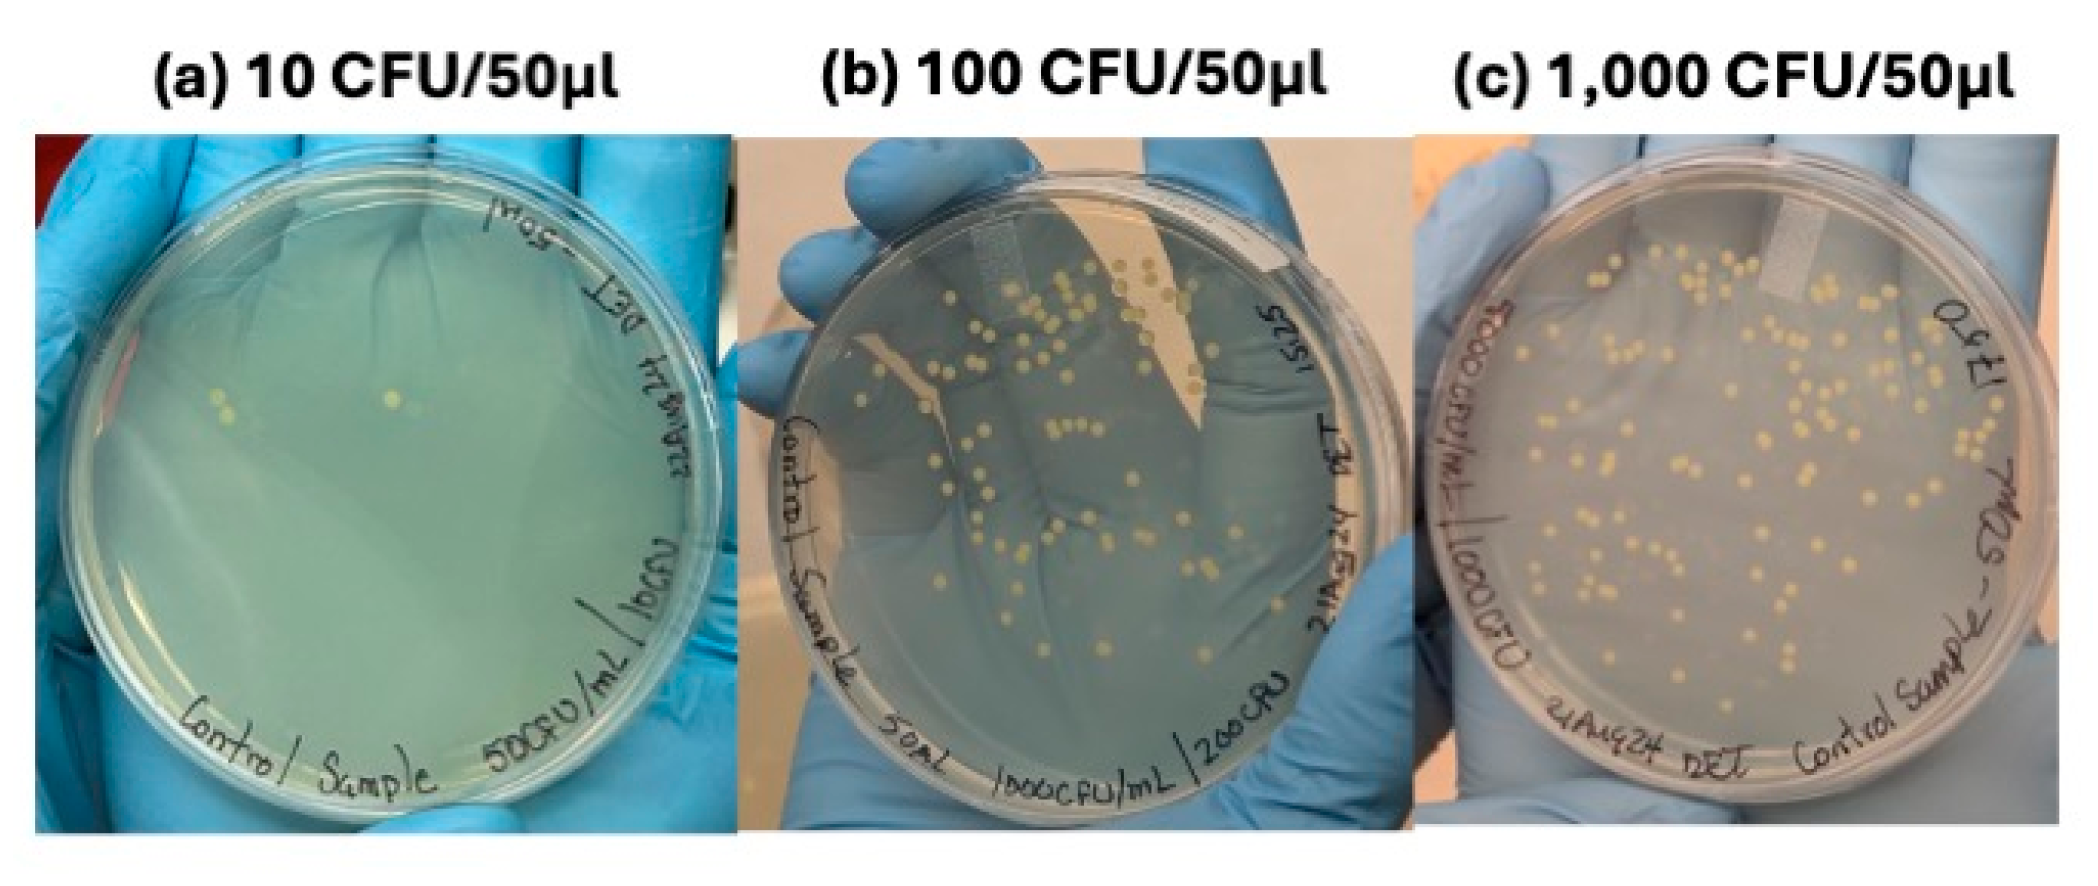
Micromachines 16 00236 g007
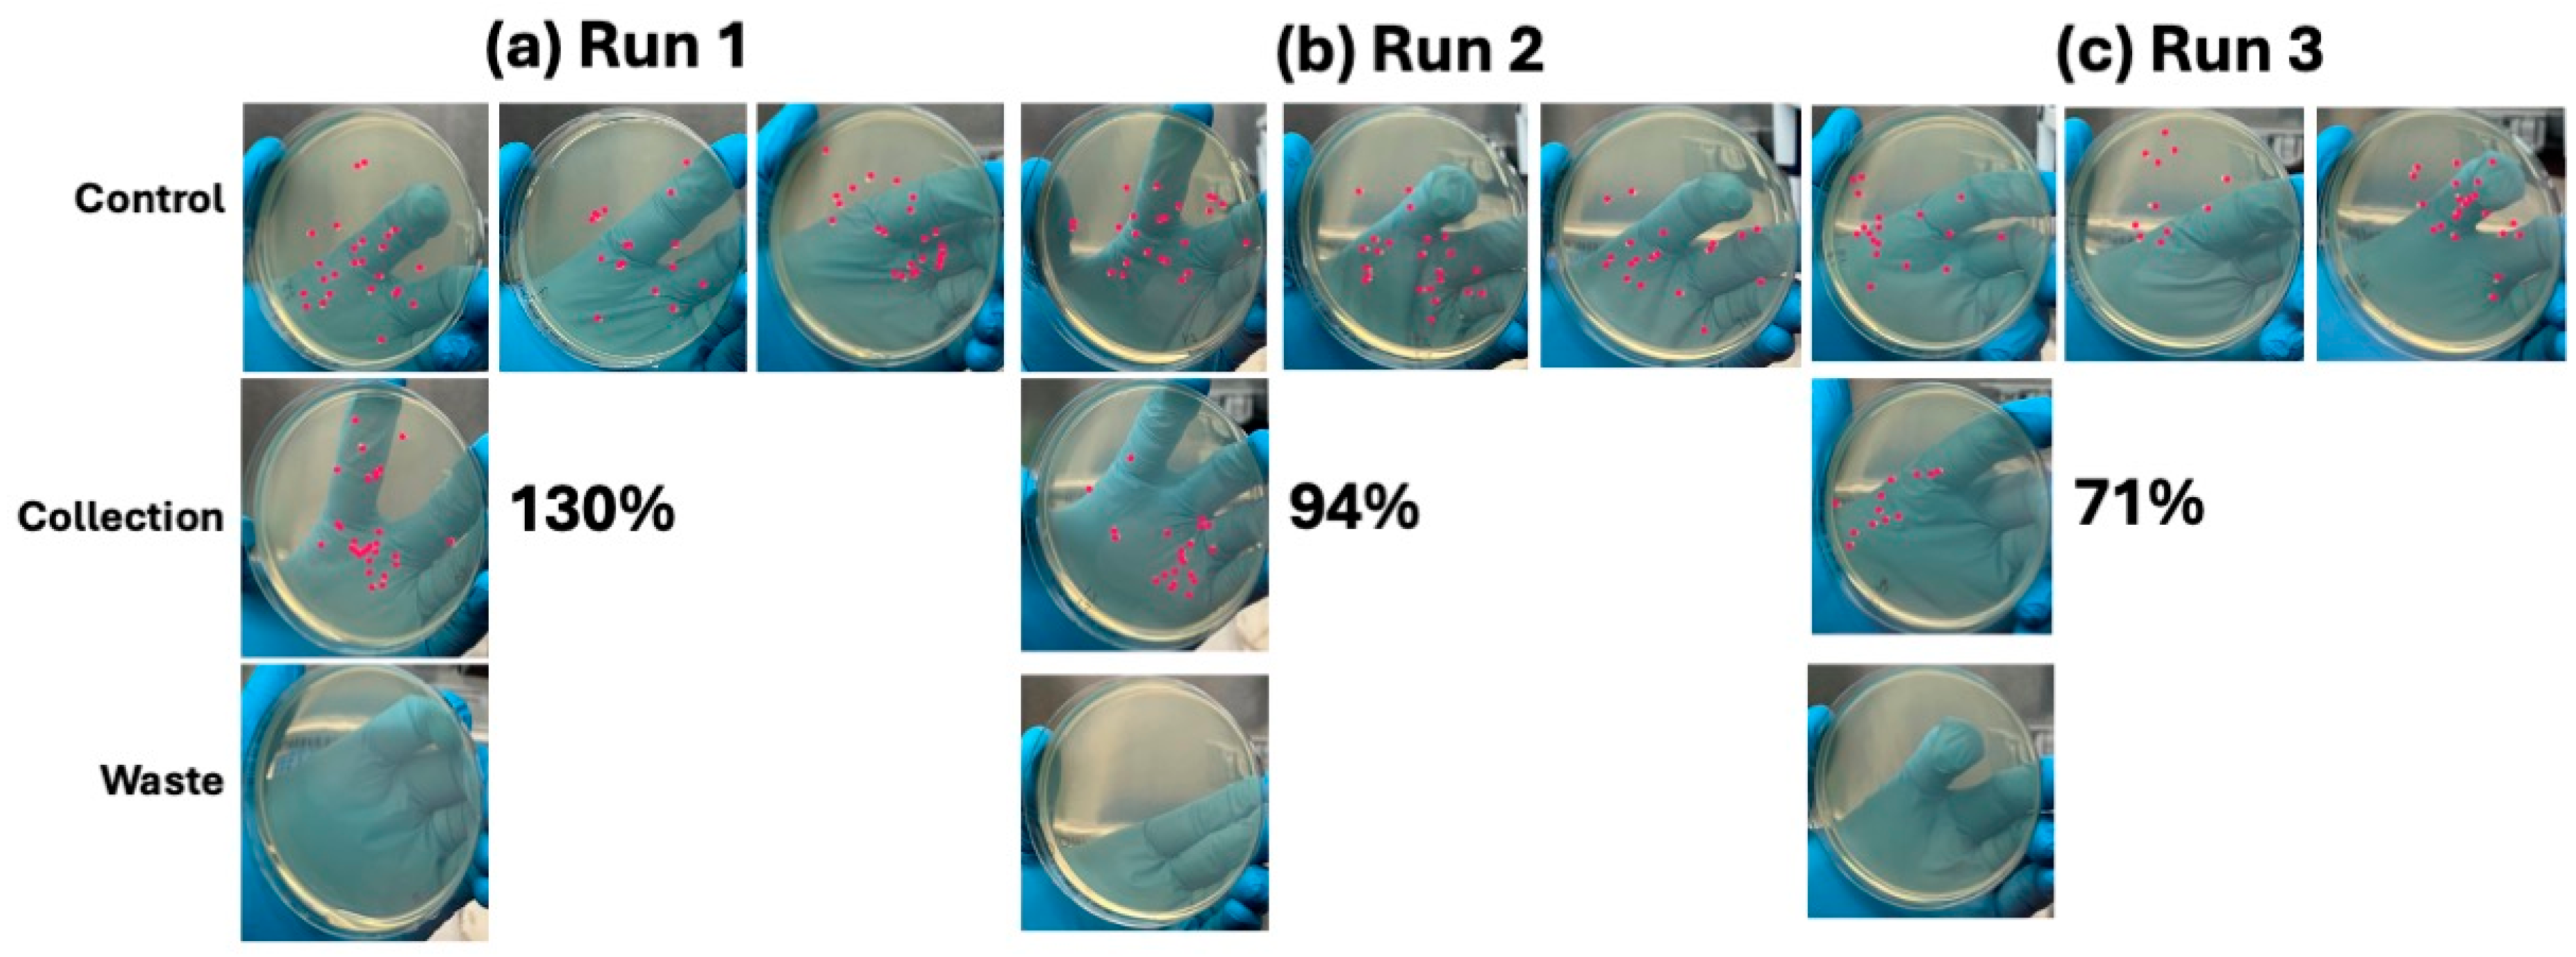
Micromachines 16 00236 g008

Abstract
Conducting detailed cellular analysis of complex biological samples poses challenges in cell sorting and recovery for downstream analysis. Label-free microfluidics provide a promising solution for these complex applications. In this work, we investigate particle manipulation on two label-free microdevice designs using cDEP to enrich E. coli from whole human blood to mimic infection workflows. E. coli is still a growing source of bacteremia, sepsis, and other infections in modern countries, affecting millions of patients globally. The two microfluidic designs were evaluated for throughput, scaling, precision targeting, and high-viability recovery. While CytoChip D had the potential for higher throughput, given its continuous method of DEP-based sorting to accommodate larger clinical samples like a 10 mL blood draw, it could not effectively recover the bacteria. CytoChip B achieved a high-purity recovery of over 98% of bacteria from whole human blood, even in concentrations on the order of <100 CFU/mL, demonstrating the feasibility of processing and recovering ultra-low concentrations of bacteria for downstream analysis, culture, and drug testing. Future work will aim to scale CytoChip B for larger volume throughput while still achieving high bacteria recovery.
1. Introduction
Understanding subpopulations of complex biological samples is critical to biology, chemistry, and healthcare research. However, conducting detailed analysis at the cellular, particle, virus, and bacteria levels poses significant challenges, especially if researchers aim to continue studying these subpopulations after manipulation from the bulk sample. Microtechnology for cell manipulation and analysis has emerged as an option for improved cell and micro-level recovery of various biological samples. These devices can be particularly useful when label-free cell sorting solutions are desired in certain biomedical and life science research applications to maintain the native characteristics of the cells and particles. These label-free applications often arise where markers are either not well established or can alter particle behavior, such as the case of microbiomes [1,2] and stem cells, respectively [3,4,5,6]. Label-based sorting can typically only be used with fixed cells [7,8]. In the case of many cell types, including neurons, fixation of cells is not desired since it causes death, which limits the sample from being used further after sorting [9,10,11]. Markers cannot be effectively used with dynamically changing cells like in pre- and post-clinical treatment samples [9,12,13] and in cases where centralized equipment such as flow cytometers may not accommodate contaminating particles like bacteria and viruses [14,15]. Even relatively passive methods such as centrifugation can prove challenging for cell viability after processing, rendering the sample no longer usable for additional study [16,17]. Further, manipulating and recovering cells without labels can provide improvement in downstream analysis like PCR, single-cell sequencing, culture, and drug toxicity studies.
One such application involves targeting and enriching bacteria, such as isolating the cancer microbiome from a tumor or enriching bacteria from blood. This process is challenging because the particles vary significantly in size, spanning an order of magnitude [18]. Additionally, traditional fluorescent antibodies are unreliable [19,20], centrifugation is difficult [18], and shared equipment cannot be used due to the risk of contamination [14]. However, enriching and recovering these microbial particles from other cells is critical to downstream analysis like PCR, colony culture, and drug treatment analysis. Here, a microdevice must precisely target and manipulate small (usually ~1–2 μm) particles from larger cells (usually ~6–8 μm), often in ultra-low concentrations (e.g., 1 bacterium per >106 cells). This requires balancing volumetric sample throughput with precision cell targeting to capture the rare events in large volumes [18,21,22]. In these applications, the experimental goal might be to effectively target and recover the rare bacteria cells for downstream PCR identification, analysis, and antimicrobial resistance detection. In contrast, in another application, sorting subpopulations of stem cells may not require consideration of size scaling since the cells are all the same order of magnitude, but the device must provide gentle, targeted enrichments where labels are ineffective due to cross-staining [23,24] and can further cause cells to begin differentiating or changing behavior [25,26]. Here, the experimental or healthcare goal might not be high-purity sorting but rather high-viability recovery for downstream analysis like single-cell sequencing, culture, and stem cell therapy development.
Thus, there are numerous microdevice designs given the complexity of biological sample inputs and the goals of particle enrichment, manipulation, and recovery. One method for label-free cell manipulation in microdevices is dielectrophoresis (DEP). DEP manipulates, sorts, and recovers cells and particles based on physical morphology and polarizability features like membrane capacitance, cytoplasm conductivity, cell size, and cell shape [27]. DEP has been used to analyze, sort, enrich, and recover [28,29] cancer stem cells [30,31,32,33,34], chemo-resistant cells [35], mesenchymal stem cells [36,37], neural stem cells [38,39,40], bacteria [41,42,43,44], live cells [45], proteins [46,47,48,49], organelles [50], extracellular vesicles [51,52,53,54], red and white blood cells [55,56,57,58,59,60], viruses [61], nanoparticles [62,63], and DNA [29,47,64], demonstrating its versatility across size scales and for precision particle manipulation and recovery. In DEP-based sorting devices, there are common features of electrodes that generate the non-uniform electric field and a sample channel for flowing and manipulating the biological sample. Contactless DEP (cDEP) takes DEP a step further by separating the biological sample completely with a thin ~10 μm membrane from the electrodes present in the device, hence the contactless name. This design better insulates samples from the electrodes, reducing Joule heating and better preserving cells’ native phenotypes [55,65]. This membrane layer allows the electrical field gradient to pass but buffers cell and particle samples to remain physically isolated [65,66,67,68,69]. As shown in the diversity of device designs in previous works, one singular DEP-based microdevice for all these applications or crossovers in particles and cells is not feasible to accommodate the varying experimental goals, sample inputs, and manufacturing requirements. For enriching bacteria, others have demonstrated feasibility using impedance cytometry [70,71,72], electro-photonic traps [73], acoustophoresis [74], or microbalances [75] on microfluidic devices, demonstrating valuable feasibility in a variety of application spaces. Other label-free sorting microdevice designs exist, such as deterministic lateral displacement (DLD) or inertial focusing, but these methods often suffer from a lack of sorting purity and the inability to sort across size scales since they rely heavily on size-based physics [76,77,78,79,80,81].
In this work, we investigate particle manipulation on two label-free microdevice designs using cDEP to enrich Escherichia coli (E. coli) from whole human blood to mimic infection workflows. E. coli is still a growing source of bacteremia, sepsis, and other infections in modern countries and impacts 47–50 million patients globally each year [82,83,84,85,86]. Strategies to faster isolate and identify the presence of the bacteria remain important to combat deadly hospital-acquired infections, which account for one in three deaths [87,88,89,90]. Compounding this challenge is the growing antimicrobial resistance globally, contributing to one million patient deaths in 2019 alone [91,92,93,94]. Here, the goal was to enrich very low concentrations of bacteria simulating bacteremia and sepsis, on the order of <100 colony forming units (CFU) per mL of whole human blood, with high enrichment efficiency and recovery of the bacteria to mimic bloodstream infection detection and sample prep for downstream analysis. In particular, the goal was to recover >90% of the bacteria present in whole blood while aiming to scale the high-purity enrichment to standard clinical blood samples of ~10 mL in volume. Experiments investigated a batch-based sorting device, CytoChipTM B, and a continuous sorting device, CytoChip D, on the CytoR1TM platform. The CytoR1 provides an integrated benchtop system with swappable, plug-and-play microtechnology devices deploying DEP for label-free sorting. Enrichment and recovery of E. coli from diluted whole human blood was evaluated with downstream plating, fluorescent microscopy, and colony counting. We ultimately evaluated the two CytoChip device designs in their ability to achieve the clinically relevant experimental goals of precision bacteria enrichment, highly viable bacteria recovery, and scaling for larger sample volume throughput starting from whole blood.
2. Materials and Methods
2.1. Device Geometry and Manufacturing
CytoChip B (CytoRecovery, Blacksburg, VA, USA) was assembled using the processes previously described and with the geometry shown in Figure 1a–c [95,96]. Briefly, devices were designed in AutoCAD 2024 (Autodesk, San Francisco, CA, USA) and fabricated using standard photolithography to pattern silicon wafer molds. Deep reactive ion etching (DRIE) was performed by the University of Florida’s Nanoscale Research Facility (NRF) to produce the main channel and electrode channel layers on separate silicon wafers (University Wafer, South Boston, MA, USA) to a height of 50 μm. Etched wafers were treated with trichloro(1H,1H,2H,2H-perfluorooctyl) silane (Thermo Fisher Scientific, Waltham, MA, USA) following fabrication for easier polymer liftoff. Dow Sylgard 184 (Dow Chemicals, Midland, MI, USA), hereafter referred to as polydimethylsiloxane (PDMS), liquid base, and curing agent were combined in a 10:1 ratio and mixed for 8 min at 1000 rpm (Caframo Petite Stirrer, Alaveta, Branchburg, NJ, USA). Degassed polymer was poured onto the silicon master wafers at specific weights to control for thickness and create electrode and sample channel layers, then cured at 110 °C for 30 min. To make the membrane layers, a 5:1 ratio of polymer base to curing agent was mixed as above, and the polymer was statically spun (Model WS-650Mz-23NPPB, Laurell Technologies, Lansdale, PA, USA) at 4000 rpm onto a blank silicon wafer to obtain a 14 μm membrane thickness. The electrode layer was first bonded to the membrane layer using 1 min of air plasma at 0.6 Torr (Harrick Plasma, Ithaca, NY, USA) treatment and subsequently allowed to sit overnight at room temperature. Then, channel layers were bonded to the electrode–membrane layer using another air plasma treatment with guiding visual alignment marks. Fully assembled devices were allowed to sit overnight. Finally, electrode channels were filled with a fusible metal alloy (Thermo Fisher Scientific).
Figure 1.
CytoChip B geometry and design features. (a) In this work, the width between the electrodes, w, was held constant at 3.4 mm. (b) Close-up of the pillars located in the sample channel and (c) the three-layer stack up.
CytoChip D (CytoRecovery) was manufactured as previously described with the geometries shown in Figure 2a,b below [38,97]. Briefly, devices were designed in AutoCAD (Autodesk) and fabricated using standard photolithography to pattern silicon wafer molds. Multi-layered SU-8 2025 (Kayaku, Tokyo, Japan) fabrication was conducted at the UF’s NRF to various final heights of the combined layers A and B to form the main channel. Etched wafers were treated with trichloro(1H,1H,2H,2H-perfluorooctyl) silane (Thermo Fisher Scientific) following fabrication for easier polymer liftoff. PDMS liquid base and curing agent were combined in a 10:1 ratio and assembled as described above. Degassed polymer was poured onto the silicon master wafer at specific weights to control for thickness and create sample channel layers and cured at 110 °C for 40 min. Glass electrode layers were manufactured at UF’s NRF using electron-beam physical vapor deposition or sputtering of titanium (200 Å) and gold (1000 Å). To make the membrane layers, a 5:1 ratio of polymer base to curing agent was mixed as above and then statically spun directly onto the glass electrode layers at 8000 rpm (Model WS-650Mz-23NPPB, Laurell Technologies). The electrode and membrane layers were then cured for 15–20 min at 90 °C. Finally, the electrode–membrane layer was visually aligned under a microscope and bonded to the main channel layer after 1 min of air plasma treatment (Harrick Plasma). Fully assembled devices were heated for 1 min at 80 °C and then allowed to sit at room temperature overnight before experimental testing.
Figure 2.
CytoChip D geometry and design features. (a) depicts top view of assembled, multi-layer device while (b) depicts the multi-layer channel, membrane, and electrode stack up. In this work, the total channel height was initially 70 μm (30 μm channel A layer, 40 μm channel B layer). Subsequent testing varied channel A from 20 to 50 µm and channel B from 30 to 50 µm in height. All other geometry features remained consistent, including hydrophoretic channel width (500 μm), electrode number (120), electrode spacing (65 μm), electrode width (35 μm), sorting channel width (1500 μm), and sorting channel length (13,200 μm).
Both CytoChip B and D employ DEP-based sorting as previously modeled and described [38,96]. In this work, the field gradients were modeled in COMSOL Multiphysics’ v6.1 (COMSOL, Inc., Burlingotn, MA, USA) electric currents module. A frequency domain sweeping 10 kHz to 15 MHz was input with an extra fine physics-controlled mesh to output the field strength. The conductivity and permittivity for all materials used are shown in Table 1 below. The respective field strengths were estimated to be 1.1 × 1016 V/m in CytoChip B and 4.4 × 1018 V/cm in CytoChip D.
Table 1.
Materials properties used for COMSOL field strength simulations of CytoChips B and D.
2.2. Biological Sample Preparation
E. coli bacteria expressing green fluorescent protein (GFP) were thawed from frozen aliquots and cultured in suspension as recommended by the manufacturer (ATCC (Manassas, VA, USA) 25922GFP). Lysogeny Broth (LB) (Sigma-Aldrich, St. Louis, MO, USA) was prepared using manufacturer protocols, autoclaved for 15 min, and allowed to fully cool prior to experimental use. To the LB broth, a final concentration of 100 µg/mL ampicillin (Millipore Sigma, Burlington, MA, USA) was added. In summary, one frozen aliquot of ~1 × 106 bacteria/mL was thawed rapidly from −80 °C. From the thawed sample aliquot, 100 µL of bacteria was suspended in 5 mL warmed LB broth in a sterile, vented tube (Bio-One Round Bottom Polypropylene Culture Tube Vented Stopper, Greiner, Kremsmünster, Austria) using aseptic techniques. The culture tube was grown at 37 °C, 150 rpm for 2 h to obtain a revival culture. After 2 h, 100 µL of revival culture was transferred to a fresh tube containing 8 mL of warmed LB broth and grown into an OD600 (test culture) after approximately an additional 80 min at 37 °C and 150 rpm. OD values were converted from measurements taken on a calibrated McFarland reader (DensiCHECK Plus, Biomerieux, Marcy-l’Étoile, France).
Healthy, human donor whole blood was obtained from Precision for Medicine (Mansfield, MA, USA) in ethylenediamine tetra acetic acid (EDTA) sterile tubes. Precision for Medicine is an FDA-registered blood establishment that follows all ethical requirements for donors in terms of human subject compliance and obtaining informed consent for their blood products for research use. Initially, frozen blood samples were tested in the feasibility studies. Upon workflow optimization, fresh blood samples were used, which more closely represents a clinical laboratory scenario. Frozen blood was stored at −20 °C and used immediately upon thawing. All fresh blood was stored at 4 °C until experimental use and was not used beyond 3 days since healthy donor donation. The fresh blood was warmed to room temperature before testing to standardize conductivity readings.
CytoBufferTM formulations were tested for washing and utility in experimentation to decrease sample coagulation, sustain bacteria viability, and reduce sample conductivity to allow DEP-based sorting [98]. CytoBuffers H and I were used to wash the sample. CytoBuffer I contains Triton-X 100 and anticoagulant acid citrate dextrose solution A (ACD-A) for lysing the red blood cells and preventing the platelets from coagulating, respectively, whereas CytoBuffer H contains only the ACD-A additive and sucrose. CytoBuffers H and I were measured to be <70 µS/cm (LAQUAtwin-EC-11, Horiba, Kyoto, Japan) upon mixing and were stored at 4 °C for up to 14 days.
Whole blood was rocked continuously on a small 3D rotator (Thermo Fisher Scientific). Following a minimum of 20 min of rocking and thawing at room temperature, whole blood was processed for final dilution into CytoBuffer J, which contains the same ingredients as CytoBuffer H but also includes an anti-fouling agent to reduce cell fouling. First, 500 µL whole blood was washed into 500 µL CytoBuffer I and centrifuged at 6000× g for 3 min (accuSpin micro 17, Thermo Fisher Scientific). Supernatant was removed, and 900 µL fresh CytoBuffer H was added to gently resuspend the whole blood and centrifuged again at the conditions above. Supernatant was again removed from the whole blood, which was resuspended a final time into fresh CytoBuffer J to desired concentrations. After two washes, diluted whole blood was counted (Countess 3FL, Thermo Fisher Scientific), and the suspension was adjusted to a final concentration of 1–2 × 106 cells/mL. When desired, bacteria were then added into the diluted blood sample to desired CFU/mL concentrations. Validation of the CFU/mL dilution of bacteria into the blood was conducted and confirmed first by independently processing bacteria only into CytoBuffers, followed by plating the resulting samples to confirm colony counts. After processing into CytoBuffer, bacteria were streaked onto LB agar plates with 100 µg/mL ampicillin (Thermo Fisher Scientific) and incubated at 37 °C with 5% CO2 (Heracell Vios 160i, Thermo Fisher Scientific). After 16+ h, colonies were counted for viability and concentration confirmation (n = 3). For all experiments, the final conductivity of the input sample and blank CytoBuffer J were measured to be <100 µS/cm. Two 1 mL syringes (NORM-JECT, Henke Sass Wolf, Tuttlingen, Germany) were loaded with the prepared sample in CytoBuffer J and blank CytoBuffer J, respectively.
Initially, diluted whole human blood or E. coli bacteria were independently loaded onto the CytoChip B and D designs to investigate their dielectrophoretic responses. Highly concentrated samples of bacteria and whole blood (1000+ CFU/mL and 2 × 106 cells/mL, respectively) in CytoBuffer J were used for response characterization on the two investigated microdevice designs. Following characterization, E. coli bacteria were contrived into the diluted whole human blood sample. A final target bacteria concentration of 25 CFU/mL in 100 µL of diluted whole blood sample in CytoBuffer J was used to obtain device design performance.
2.3. Experimental Procedures on CytoR1 Platform and CytoChip Performance Evaluation
The CytoR1 platform is a benchtop instrument for integrated cell enrichment and recovery, as shown in Figure 3. The platform consists of a Chip Interfacing System (CIS) to easily plug and play various microdevice designs electronically and fluidically (D6422, CytoRecovery). Additionally, the CytoGeneratorTM (CytoRecovery), a wideband power amplifier, produces 5 kHz–15 MHz and 2 Vpp–640 Vpp for dielectrophoretic field gradient generation [99,100]. Two syringe pumps (New Era 1000-US) control the sample, and blank CytoBuffer entry and all the hardware are controlled by CytoSoftwareTM v1.1.5.4 (CytoRecovery, Blacksburg, VA, USA). For this work, experiments were visualized using a fluorescent microscope with GFP and Texas Red filter light cubes (Evos M5000, Thermo Fisher Scientific).
Figure 3.
CytoR1 platform setup for experimental testing of CytoChips B and D for label-free, cDEP enrichment of E. coli from whole human blood.
Once the bacteria were added into the diluted blood sample and blank CytoBuffer reagent were loaded into syringes as above, they were each connected to a 20-gauge needle (SANANTS 0.5-inch, Amazon, China) and 1/32-inch inner diameter PTFE tubing (Master Flex, Gelsenkirchen, Germany). CytoChip priming was conducted using standard 70% ethanol (Thermo Fisher Scientific) loaded into a 2 mL syringe (Nevershare, Exchange Supplies, Dorchester, UK) connected via the same needle and tubing as samples to remove all bubbles from the microdevices. Once primed and all bubbles removed, blank CytoBuffer J was flushed through the chips to ensure no toxicity to the samples. For CytoChip B, flow rates were varied from 1 to 5 μL/min for the sample and 0.1 μL/min for blank CytoBuffer. For CytoChip D, flow rates were varied from 1 to 20 μL/min for the sample.
Once loaded onto the CytoR1 platform using one of the two CytoChip designs, E. coli bacteria were enriched from the diluted whole human blood. The CytoGenerator was tuned to a variety of parameters to determine a high-purity sort and recovery of the bacteria, where the blood cells were considered waste for the purpose of detecting potential bloodstream infections. Frequency (10 kHz–15 MHz) and voltage (10 Vpp–640 Vpp) parameters were swept and explored to locate where >90% of E. coli was experiencing DEP, which was determined to be effective trapping on each chip design. For CytoChip B, replicates were batched and collected after 30–60 min of run time. A wash step using blank CytoBuffer J at 5 μL/min was conducted between waste and target bacteria collection to clear the device of any remaining sample and ensure high recovery. For CytoChip D, 20–60 min of continuous sample processing was considered one replicate.
Recovered bacteria from the waste and collection streams were initially plated into 96-well flat bottom plates (GenClone, Genesee Scientific, El Cajon, CA, USA) and incubated as above. After 16+ h of post-sorting growth, wells were imaged on the scope above. As workflows were optimized, recovered bacteria from the waste and collection were both streaked onto LB agar plates with 100 µg/mL ampicillin (Thermo Fisher Scientific) and incubated as above.
2.4. Statistical Analysis
All counts shown were conducted in triplicate, with final counts shown as the average ± standard error of the mean (SEM).
3. Results
3.1. Sample Preparation Validation
E. coli was plated, grown, and counted after processing in CytoBuffer to achieve final concentrations of 1–1000 CFU/mL and a conductivity below 100 µS/cm. Samples <20 CFU/mL varied significantly in colony count (±100%) and so were considered unreliable given the losses of the sample during processing and transfer to the plates. Samples >200 CFU/mL resulted in too high of a confluency on the plates, so counts could not be obtained as colonies merged. E. coli concentrations of 20–200 CFU/mL were found to be consistent (±20%) and deemed repeatable and accurate for processing, experimentation, and subsequent plating and counting. These initial seeding experiments further validated that the bacteria grew as expected after the washing and processing steps into low conductivity CytoBuffers.
3.2. CytoChip B and D Initial Performance Evaluation
CytoChip D was deployed continuously such that the bacteria migrated (positive DEP) into the center outlet channel while the blood cells passed into the two outer waste channels (no DEP). Initially, this design was selected to afford flexibility in scaling to larger volumes that would be present in clinical samples, like 10 mL blood draws. When optimized, 500 kHz and 578 Vpp were used to achieve the best bacteria enrichment and recovery. Initially, failure was observed in CytoChip D’s performance because the bacteria and blood cells escaped the hydrophoretic focusing upstream of the DEP-based sorting, meaning the bacteria and cells were not actually experiencing DEP-based sorting but rather flowing directly through the device under drag. An example of this drag-dominated phenomenon is shown in Supplementary Video S1. The initial evaluation results of bacteria enrichment, plating, and microscopy imaging from diluted whole human blood on CytoChip D are shown in Figure 4.
Figure 4.
CytoChip D imaging results from preliminary E. coli from diluted human whole blood enrichment at 500 kHz and 578 Vpp. Here, GFP microscopy imaging shows just the bacteria recovery after 20, 40, and 60 min across the collection and waste channels. Initial results indicate a lot of the bacteria was not enriched and ended up in the waste stream, but it is also important to note that the control sample also appeared lower in concentration than anticipated. These results indicated alterations to the device geometry were needed for further optimization.
CytoChip B was deployed such that the bacteria were trapped (positive DEP) on the pillars while the blood cells passed through. When optimized, 400 kHz and 648 Vpp were determined to achieve the best bacteria enrichment and recovery, as shown in Supplementary Video S2. Using this workflow, the bacteria were effectively trapped at a high rate, but the flow rate was initially maximized at only 1–2 μL/min, meaning scaling to larger volume samples would require some innovative approaches. Regardless, CytoChip B showed improved enrichment over CytoChip D in initial experimentation. The initial experimental results of bacteria enrichment, plating, and imaging from diluted whole human blood on CytoChip B are shown in Figure 5.
Figure 5.
CytoChip B imaging results from preliminary enrichment of E. coli from diluted human whole blood at 400 kHz and 648 Vpp. Here, GFP imaging shows just the bacteria recovery after ~30 and ~60 min in the collection and waste batches. Initial results indicate enrichment from the control into the collection batch, driving the decision to continue with the device geometry and further optimize the workflow on CytoChip B in subsequent testing.
3.3. CytoChips Optimization for High-Purity Bacteria Enrichment and Recovery
Following initial experimental evaluation, both CytoChip workflows and microfeature geometries were further developed to improve performance. For CytoChip B, the focus was on improving the volumetric throughput since this design is limited by batching times and speeds. For CytoChip D, the device geometry was altered to focus on improving the enrichment efficiency and ensuring the bacteria and blood cells could be hydrophoretically focused for DEP-based sorting downstream. Lower concentrations (30,000 and 1000 CFU/mL after dilution) were tested on the evolved workflows on both CytoChip B and D.
First, CytoChip B flow rates were increased as much as possible to continue building toward higher volumetric throughput. A maximum processing speed of 3.3 μL/min was obtained with continued, high enrichment of the bacteria in the collection batch, as shown in Figure 6b. Additionally, low concentrations of bacteria were found in the waste batch.
Figure 6.
CytoChips microscopy imaging results from optimized workflows of E. coli from diluted human whole blood enrichment. (a) depicts the control stock and two dilutions of E. coli in whole blood. (b) demonstrates the enrichment of E. coli into the collection batch with few bacteria in the waste batch in CytoChip B. (c) illustrates CytoChip D still contains a lot of bacteria that are leaking into the waste channels and that little are recovered in the collection channel despite altering the channel height to attempt to better focus the sample upstream of the DEP sorting region.
To combat the lack of focusing in CytoChip D, altered geometries were made with 60–70 µm total heights to improve the hydrophoretic focusing of the bacteria and blood cells upstream of the DEP sorting region. Specifically, channel A was varied from 20 to 50 µm, and channel B was varied from 30 to 50 µm in height. However, these altered designs still resulted in low enrichment, with high concentrations of bacteria ending up in the waste streams over the collection stream, as shown in Figure 6c.
3.4. Toward a Clinically Relevant Evaluation of the Optimized CytoChip B Workflow
Given the initial performance evaluation, workflow optimization, and design changes, CytoChip B was shown to have a better preliminary enrichment for bacteria from whole blood. To mimic a more clinically relevant sample, a <50 CFU/mL concentration of bacteria was in the diluted whole blood with 100 µL of total sample volume processed. To validate the appropriate dilution schemes and plating procedures, controls were first obtained for several orders of magnitude of bacteria concentration, as shown in Figure 7. During this process, it was observed that concentrations ≤10 CFU/mL had high variability (±100%) due to the losses in processing and subsequent plating. Concentrations of ≥20 CFU/mL were found to be significantly less variable (±30%).
Figure 7.
Demonstration of E. coli dilution at various orders of magnitude, including (a) ~10 CFU/50 µL, (b) 100 CFU/50 µL, and (c) 1000 CFU/50 µL. Cultures were streaked, plated, and incubated for 16+ h of growth.
To achieve the appropriate dilutions of bacteria in whole blood, optimized workflow enrichments were conducted on ~25 CFU/100 µL samples using the 3.3 µL/min max flow rate, resulting in 30 min to batch the full sample. Following enrichment, the waste batch and collection batch were streaked and plated to determine the recovery percentage and enrichment purity. As shown in Figure 8a–c, 21 ± 9 bacteria were recovered in the collection batch, with 0 ± 0 bacteria recovered in the waste also containing the blood cells. This equated to a 98.4% recovery efficiency of the bacteria on CytoChip B’s optimized workflow, as shown in Figure 9.
Figure 8.
Results of the optimized CytoChip B workflow using 3.3 µL/min flow rate resulting in 30 min to batch a 100 µL sample containing 25 CFU bacteria. For each replicate run (a–c), multiple controls, the collection batch, and the waste batch were recovered, streaked, and grown for 16+ h. Red dots indicate counted colonies for data analysis, and the recovery percentage is taken relative to the average of the three controls for each experimental run.
Figure 9.
Optimized CytoChip B workflow achieved, on average, a 98.6% recovery of 25 CFU of E. coli in 100 µL diluted whole human blood. High variability in plating is known to be one challenge of colony counting correlations, which can cause higher standard errors in the mean [101].
4. Discussion
The complexity of biological samples in healthcare and biotechnology applications can prove challenging when there is a desire to understand subpopulations of cells and particles and their relative interactions, behaviors, and patterns. In this study, we explored cDEP as a label-free method for enriching cells and particles from heterogeneous suspensions. Label-free sorting is highly valuable in workflows where the cells or particles are going to be further studied downstream in analyses like sequencing, PCR, culture, and drug toxicity testing. In this work, we aimed to enrich E. coli from whole human blood to target and recover the bacteria for downstream analysis, mimicking clinical workflows for sepsis and bloodstream infection detection. Of important note, spiked samples in healthy blood were used, which does not fully account for the expected clinical variability in patient-obtained samples, which will need to be further explored to validate this initial work. Other environmental factors and variables like temperature control, other bacteria strains, blood draw to experimental time, humidity control, and blood collection tube coatings could further alter these findings as complexity is increased. The experimental goals were complex, requiring a balance between high-viability recovery without labels and large volume throughput. Therefore, two DEP-based sorting microdevices, CytoChips B and D, were investigated for their unique advantages and disadvantages in enriching E. coli from healthy donor human whole blood. The two designs were evaluated for throughput, scaling, precision targeting, and high-viability recovery. While CytoChip D had the potential for higher throughput, given its continuous method of DEP-based sorting to accommodate larger clinical samples like a 10 mL blood draw, it could not effectively recover the bacteria. In CytoChip D, a significant sample was lost in the waste due to inadequate focus within the hydrophoretic region. Even with design alterations to improve this fluidic focusing upstream of the DEP sorting, CytoChip D underperformed in bacteria enrichment and recovery. Of note, CytoChip D was designed for mammalian cells and not for smaller cells such as bacteria, and additional design modifications may be necessary to target small cells [38,39]. Though it did not work in this particular application, CytoChip D affords many advantages in other applications like sorting stem, cancer, and immune cells. CytoChip B showed consistent, high-purity recovery of bacteria, even in concentrations on the order of <100 CFU/mL. CytoChip B achieved over 98% viable recovery of the E. coli while depleting the blood cells, demonstrating the feasibility of processing and recovering ultra-low concentrations of bacteria for downstream analysis, culture, and drug testing. While promising, scaling the precision recovery of CytoChip B for large-volume samples could prove challenging in moving toward clinical applicability. Future work will investigate parallelizing CytoChip B or lengthening the sample channel to provide larger volume throughputs. Additionally, integrating other label-free sorting designs, such as deterministic lateral displacement (DLD), could be investigated in combination with CytoChip B to balance bulk and higher throughput sorting upstream with precision enrichments downstream. If the 10 mL clinical sample can be depleted of the high concentration of red blood cells (~40% of 10 mL) using upstream DLD or lysis, the downstream processing of ~6 mL of concentrated bacteria in the remaining plasma and buffy coat could be achieved on a four-chamber array of CytoChip B (13.2 µL/min), bringing the processing time down to 7–8 h instead of the days currently required for blood smear cultures [22,102]. Other novel processing, chemical treatments, or combinatorial solutions will likely be required to obtain rapid bacteria enrichment on the desired clinical scale of minutes to hours. In conjunction with exploring hybrid microdevice solutions, it will be important to compare other traditional methodologies and current gold standards, such as flow cytometry and blood smear cultures, to validate head-to-head comparisons.
Supplementary Materials
The following supporting information can be downloaded at: https://cloud.cytorecovery.com/s/EdxCfzo7oem4Ead (accessed on 6 February 2025), Video S1: CytoChip D Enrichment Example, Video S2: CytoChip B Enrichment Example. Video S1 Caption: Example video of E. coli and diluted whole human blood on CytoChip D. As observed, much of the cells and bacteria are not hydrophoretically focused to the outer walls of the device as designed, meaning the downstream DEP enrichment region is not performing as expected. Video S2 Caption: These two videos depict same sample being sorted. (a) The e.coli, the target, is at a concentration of 10CFU/mL, and is visualized using the green filter. (b) The whole blood sample is shown flowing past the same trap points and visualized in bright field.
Author Contributions
Conceptualization, A.R.H., D.E.T., R.V.D. and L.A.F.; methodology, A.R.H., D.E.T. and K.S.K.; validation, D.E.T. and K.S.K.; formal analysis, A.R.H.; investigation, D.E.T., K.S.K. and K.M.B.; resources, R.V.D., L.A.F. and A.R.H.; data curation, K.S.K., D.E.T. and A.R.H.; writing—original draft preparation, A.R.H.; writing—review and editing, K.S.K., K.M.B., D.E.T., R.V.D. and L.A.F.; visualization, K.S.K. and A.R.H.; supervision, A.R.H.; project administration, D.E.T. and A.R.H.; funding acquisition, A.R.H., R.V.D. and L.A.F. All authors have read and agreed to the published version of the manuscript.
Funding
This research was funded in part by the National Science Foundation Small Business Innovation Research grant number 2222933 (A.R.H. and R.V.D.) and IOS-2019400 (L.A.F.). This research was further funded in part by BLASTID, Inc. under the sub-award from the Advanced Research Projects Agency for Health (ARPA-H) Defeating Antibiotic Resistance through Transformative Solutions (DARTS) federal grant to Harvard University under award number 152048.5131858.0074.
Data Availability Statement
The data presented in this study are available upon request from the corresponding author due to privacy restrictions.
Acknowledgments
The authors thank Eva M. Schmelz (Virginia Tech) and Jessica Gilbertie (Virginia Tech) for providing the materials and equipment used in this work. We further thank Paulo A. Garcia and Thomas M. Feltrup (BLASTID, Inc.) for providing the materials and knowledge that contributed to this work.
Conflicts of Interest
D.E.T., K.S.K., K.M.B., and A.R.H. are employed by CytoRecovery, Inc. R.V.D. provides scientific advising to CytoRecovery, Inc. R.V.D. and L.A.F. hold patents in dielectrophoresis. The funders (Blastid, Inc.) were involved in the study design and writing of the manuscript but had no role in data collection, analyses, result interpretation, or the decision to publish.
References
- Bellais, S.; Nehlich, M.; Ania, M.; Duquenoy, A.; Mazier, W.; Engh, G.v.d.; Baijer, J.; Treichel, N.S.; Clavel, T.; Belotserkovsky, I.; et al. Species-Targeted Sorting and Cultivation of Commensal Bacteria from the Gut Microbiome Using Flow Cytometry under Anaerobic Conditions. Microbiome 2022, 10, 24. [Google Scholar] [CrossRef] [PubMed]
- Robinson, J.P.; Ostafe, R.; Iyengar, S.N.; Rajwa, B.; Fischer, R. Flow Cytometry: The Next Revolution. Cells 2023, 12, 1875. [Google Scholar] [CrossRef] [PubMed]
- Alexander, C.M.; Puchalski, J.; Klos, K.S.; Badders, N.; Ailles, L.; Kim, C.F.; Dirks, P.; Smalley, M.J. Separating Stem Cells by Flow Cytometry: Reducing Variability for Solid Tissues. Cell Stem Cell 2009, 5, 579–583. [Google Scholar] [CrossRef] [PubMed]
- Chandouri, B.; Naves, T.; Yassine, M.; Ikhlef, L.; Tricard, J.; Chaunavel, A.; Homayed, Z.; Pannequin, J.; Girard, N.; Durand, S.; et al. Comparison of Methods for Cancer Stem Cell Detection in Prognosis of Early Stages NSCLC. Br. J. Cancer 2024, 131, 1425–1436. [Google Scholar] [CrossRef] [PubMed]
- Golebiewska, A.; Brons, N.H.C.; Bjerkvig, R.; Niclou, S.P. Critical Appraisal of the Side Population Assay in Stem Cell and Cancer Stem Cell Research. Cell Stem Cell 2011, 8, 136–147. [Google Scholar] [CrossRef] [PubMed]
- Cao, Y.; Boss, A.L.; Bolam, S.M.; Munro, J.T.; Crawford, H.; Dalbeth, N.; Poulsen, R.C.; Matthews, B.G. In Vitro Cell Surface Marker Expression on Mesenchymal Stem Cell Cultures Does Not Reflect Their Ex Vivo Phenotype. Stem Cell Rev. Rep. 2024, 20, 1656–1666. [Google Scholar] [CrossRef]
- Martin, D.; Xu, J.; Porretta, C.; Nichols, C.D. Neurocytometry: Flow Cytometric Sorting of Specific Neuronal Populations from Human and Rodent Brain. ACS Chem. Neurosci. 2017, 8, 356–367. [Google Scholar] [CrossRef]
- Anyaegbu, C.C.; Mao, Y.; McGonigle, T.; Raja, S.; Clarke, T.; Black, A.M.B.; Solomon, T.; Fuller, K.; Fitzgerald, M. Simultaneous Flow Cytometric Characterization of Multiple Cell Types and Metabolic States in the Rat Brain after Repeated Mild Traumatic Brain Injury. J. Neurosci. Methods 2021, 359, 109223. [Google Scholar] [CrossRef] [PubMed]
- Brestoff, J.R.; Frater, J.L. Contemporary Challenges in Clinical Flow Cytometry: Small Samples, Big Data, Little Time. J. Appl. Lab. Med. 2022, 7, 931–944. [Google Scholar] [CrossRef] [PubMed]
- Matsumoto, M.; Tashiro, S.; Ito, T.; Takahashi, K.; Hashimoto, G.; Kajihara, J.; Miyahara, Y.; Shiku, H.; Katsumoto, Y. Fully Closed Cell Sorter for Immune Cell Therapy Manufacturing. Mol. Ther. Methods Clin. Dev. 2023, 30, 367–376. [Google Scholar] [CrossRef]
- Basu, S.; Campbell, H.M.; Dittel, B.N.; Ray, A. Purification of Specific Cell Population by Fluorescence Activated Cell Sorting (FACS). JoVE 2010, e1546. [Google Scholar] [CrossRef]
- Drescher, H.; Weiskirchen, S.; Weiskirchen, R. Flow Cytometry: A Blessing and a Curse. Biomedicines 2021, 9, 1613. [Google Scholar] [CrossRef]
- Cossarizza, A.; Chang, H.; Radbruch, A.; Akdis, M.; Andrä, I.; Annunziato, F.; Bacher, P.; Barnaba, V.; Battistini, L.; Bauer, W.M.; et al. Guidelines for the Use of Flow Cytometry and Cell Sorting in Immunological Studies*. Eur. J. Immunol. 2017, 47, 1584–1797. [Google Scholar] [CrossRef] [PubMed]
- Box, A.; Holmes, L.; DeLay, M.; Adams, D.; Bergeron, A.; Clise-Dwyer, K.; Cochran, M.; Guerra, R.D.R.; Meyer, E.M.; Brundage, K.M. Cell Sorter Cleaning Practices and Their Impact on Instrument Sterility. J. Biomol. Tech. 2022, 33, 3fc1f5fe.e2675d74. [Google Scholar] [CrossRef]
- Schmid, I.; Merlin, S.; Perfetto, S.P. Biosafety Concerns for Shared Flow Cytometry Core Facilities. Cytom. Part. A 2003, 56A, 113–119. [Google Scholar] [CrossRef]
- Peterson, B.W.; Sharma, P.K.; Mei, H.C.v.d.; Busscher, H.J. Bacterial Cell Surface Damage Due to Centrifugal Compaction. Appl. Environ. Microbiol. 2012, 78, 120–125. [Google Scholar] [CrossRef] [PubMed]
- Son, D.; Choi, T.; Yeo, H.; Kim, J.; Han, K. The Effect of Centrifugation Condition on Mature Adipocytes and Adipose Stem Cell Viability. Ann. Plast. Surg. 2014, 72, 589–593. [Google Scholar] [CrossRef]
- Pitt, W.G.; Alizadeh, M.; Husseini, G.A.; McClellan, D.S.; Buchanan, C.M.; Bledsoe, C.G.; Robison, R.A.; Blanco, R.; Roeder, B.L.; Melville, M.; et al. Rapid Separation of Bacteria from Blood-Review and Outlook. Biotechnol. Prog. 2016, 32, 823–839. [Google Scholar] [CrossRef] [PubMed]
- Simón-Soro, Á.; D’Auria, G.; Collado, M.C.; Džunková, M.; Culshaw, S.; Mira, A. Revealing Microbial Recognition by Specific Antibodies. BMC Microbiol. 2015, 15, 132. [Google Scholar] [CrossRef] [PubMed]
- Moor, K.; Fadlallah, J.; Toska, A.; Sterlin, D.; Balmer, M.L.; Macpherson, A.J.; Gorochov, G.; Larsen, M.; Slack, E. Analysis of Bacterial-Surface-Specific Antibodies in Body Fluids Using Bacterial Flow Cytometry. Nat. Protoc. 2016, 11, 1531–1553. [Google Scholar] [CrossRef] [PubMed]
- Pratt, E.D.; Huang, C.; Hawkins, B.G.; Gleghorn, J.P.; Kirby, B.J. Rare Cell Capture in Microfluidic Devices. Chem. Eng. Sci. 2011, 66, 1508–1522. [Google Scholar] [CrossRef]
- Costa, S.P.; Carvalho, C.M. Burden of Bacterial Bloodstream Infections and Recent Advances for Diagnosis. Pathog. Dis. 2022, 80, ftac027. [Google Scholar] [CrossRef] [PubMed]
- Kalina, T.; Lundsten, K.; Engel, P. Relevance of Antibody Validation for Flow Cytometry. Cytom. Part A 2020, 97, 126–136. [Google Scholar] [CrossRef]
- Cossarizza, A.; Chang, H.; Radbruch, A.; Abrignani, S.; Addo, R.; Akdis, M.; Andrä, I.; Andreata, F.; Annunziato, F.; Arranz, E.; et al. Guidelines for the Use of Flow Cytometry and Cell Sorting in Immunological Studies (Third Edition). Eur. J. Immunol. 2021, 51, 2708–3145. [Google Scholar] [CrossRef] [PubMed]
- Andrzejewska, A.; Jablonska, A.; Seta, M.; Dabrowska, S.; Walczak, P.; Janowski, M.; Lukomska, B. Labeling of Human Mesenchymal Stem Cells with Different Classes of Vital Stains: Robustness and Toxicity. Stem Cell Res. Ther. 2019, 10, 187. [Google Scholar] [CrossRef]
- Yale, A.R.; Kim, E.; Gutierrez, B.; Hanamoto, J.N.; Lav, N.S.; Nourse, J.L.; Salvatus, M.; Hunt, R.F.; Monuki, E.S.; Flanagan, L.A. Regulation of Neural Stem Cell Differentiation and Brain Development by MGAT5-Mediated N-Glycosylation. Stem Cell Rep. 2023, 18, 1340–1354. [Google Scholar] [CrossRef] [PubMed]
- Pethig, R. How Does Dielectrophoresis Differ from Electrophoresis? In Dielectrophoresis: Theory, Methodology and Biological Applications, 1st ed.; Wiley: Hoboken, NJ, USA, 2017; pp. 31–48. [Google Scholar] [CrossRef]
- Gagnon, Z.R. Cellular Dielectrophoresis: Applications to the Characterization, Manipulation, Separation and Patterning of Cells. Electrophoresis 2011, 32, 2466–2487. [Google Scholar] [CrossRef] [PubMed]
- Jubery, T.Z.; Srivastava, S.K.; Dutta, P. Dielectrophoretic Separation of Bioparticles in Microdevices: A Review. Electrophoresis 2014, 35, 691–713. [Google Scholar] [CrossRef]
- Lin, E.; Rivera-Baez, L.; Fouladdel, S.; Yoon, H.J.; Guthrie, S.; Wieger, J.; Deol, Y.; Keller, E.; Sahai, V.; Simeone, D.M.; et al. High-Throughput Microfluidic Labyrinth for the Label-Free Isolation of Circulating Tumor Cells. Cell Syst. 2017, 5, 295–304.e4. [Google Scholar] [CrossRef] [PubMed]
- Hyun, K.-A.; Jung, H.-I. Microfluidic Devices for the Isolation of Circulating Rare Cells: A Focus on Affinity-Based, Dielectrophoresis, and Hydrophoresis. Electrophoresis 2013, 34, 1028–1041. [Google Scholar] [CrossRef]
- Alinezhadbalalami, N.; Douglas, T.A.; Balani, N.; Verbridge, S.S.; Davalos, R.V. The Feasibility of Using Dielectrophoresis for Isolation of Glioblastoma Subpopulations with Increased Stemness. Electrophoresis 2019, 40, 2592–2600. [Google Scholar] [CrossRef] [PubMed]
- Salmanzadeh, A.; Romero, L.; Shafiee, H.; Gallo-Villanueva, R.C.; Stremler, M.A.; Cramer, S.D.; Davalos, R.V. Isolation of Prostate Tumor Initiating Cells (TICs) through Their Dielectrophoretic Signature. Lab. Chip 2012, 12, 182–189. [Google Scholar] [CrossRef] [PubMed]
- Adams, A.A.; Okagbare, P.I.; Feng, J.; Hupert, M.L.; Patterson, D.; Göttert, J.; McCarley, R.L.; Nikitopoulos, D.; Murphy, M.C.; Soper, S.A. Highly Efficient Circulating Tumor Cell Isolation from Whole Blood and Label-Free Enumeration Using Polymer-Based Microfluidics with an Integrated Conductivity Sensor. J. Am. Chem. Soc. 2008, 130, 8633–8641. [Google Scholar] [CrossRef]
- Rane, A.; Jarmoshti, J.; Siddique, A.-B.; Adair, S.; Torres-Castro, K.; Honrado, C.; Bauer, T.W.; Swami, N.S. Dielectrophoretic Enrichment of Live Chemo-Resistant Circulating-like Pancreatic Cancer Cells from Media of Drug-Treated Adherent Cultures of Solid Tumors. Lab Chip 2023, 24, 561–571. [Google Scholar] [CrossRef]
- Tsai, T.; Vyas, P.D.; Crowell, L.L.; Tran, M.; Ward, D.W.; Qin, Y.; Castro, A.; Adams, T.N.G. Electrical Signature of Heterogeneous Human Mesenchymal Stem Cells. Electrophoresis 2024, 45, 1562–1573. [Google Scholar] [CrossRef]
- Lee, A.P.; Aghaamoo, M.; Adams, T.N.G.; Flanagan, L.A. It’s Electric: When Technology Gives a Boost to Stem Cell Science. Curr. Stem Cell Rep. 2018, 4, 116–126. [Google Scholar] [CrossRef] [PubMed]
- Jiang, A.Y.L.; Yale, A.R.; Aghaamoo, M.; Lee, D.-H.; Lee, A.P.; Adams, T.N.G.; Flanagan, L.A. High-Throughput Continuous Dielectrophoretic Separation of Neural Stem Cells. Biomicrofluidics 2019, 13, 064111. [Google Scholar] [CrossRef] [PubMed]
- Adams, T.N.G.; Jiang, A.Y.L.; Vyas, P.D.; Flanagan, L.A. Separation of Neural Stem Cells by Whole Cell Membrane Capacitance Using Dielectrophoresis. Methods 2018, 133, 91–103. [Google Scholar] [CrossRef] [PubMed]
- Lu, J.; Barrios, C.A.; Dickson, A.R.; Nourse, J.L.; Lee, A.P.; Flanagan, L.A. Advancing Practical Usage of Microtechnology: A Study of the Functional Consequences of Dielectrophoresis on Neural Stem Cells. Integr. Biol. 2012, 4, 1223–1236. [Google Scholar] [CrossRef] [PubMed]
- Lapizco-Encinas, B.H.; Simmons, B.A.; Cummings, E.B.; Fintschenko, Y. Dielectrophoretic Concentration and Separation of Live and Dead Bacteria in an Array of Insulators. Anal. Chem. 2004, 76, 1571–1579. [Google Scholar] [CrossRef]
- Lapizco-Encinas, B.H.; Simmons, B.A.; Cummings, E.B.; Fintschenko, Y. Insulator-Based Dielectrophoresis for the Selective Concentration and Separation of Live Bacteria in Water. Electrophoresis 2004, 25, 1695–1704. [Google Scholar] [CrossRef]
- Li, H.; Bashir, R. Dielectrophoretic Separation and Manipulation of Live and Heat-Treated Cells of Listeria on Microfabricated Devices with Interdigitated Electrodes. Sens. Actuators B Chem. 2002, 86, 215–221. [Google Scholar] [CrossRef]
- Toma, A.d.; Brunetti, G.; Chiriacò, M.S.; Ferrara, F.; Ciminelli, C. A Novel Hybrid Platform for Live/Dead Bacteria Accurate Sorting by On-Chip DEP Device. Int. J. Mol. Sci. 2023, 24, 7077. [Google Scholar] [CrossRef] [PubMed]
- Shafiee, H.; Sano, M.B.; Henslee, E.A.; Caldwell, J.L.; Davalos, R.V. Selective Isolation of Live/Dead Cells Using Contactless Dielectrophoresis (CDEP). Lab Chip 2010, 10, 438. [Google Scholar] [CrossRef]
- Kim, D.; Sonker, M.; Ros, A. Dielectrophoresis: From Molecular to Micrometer-Scale Analytes. Anal. Chem. 2019, 91, 277–295. [Google Scholar] [CrossRef]
- Nakano, A.; Chao, T.-C.; Camacho-Alanis, F.; Ros, A. Immunoglobulin G and Bovine Serum Albumin Streaming Dielectrophoresis in a Microfluidic Device. Electrophoresis 2011, 32, 2314–2322. [Google Scholar] [CrossRef]
- Hayes, M.A. Dielectrophoresis of Proteins: Experimental Data and Evolving Theory. Anal. Bioanal. Chem. 2020, 412, 3801–3811. [Google Scholar] [CrossRef]
- Gustafson, K.T.; Sayar, Z.; Le, H.; Gustafson, S.L.; Gower, A.; Modestino, A.; Ibsen, S.; Heller, M.J.; Esener, S.; Eksi, S.E. Cyc-DEP: Cyclic Immunofluorescence Profiling of Particles Collected Using Dielectrophoresis. Electrophoresis 2022, 43, 1784–1798. [Google Scholar] [CrossRef] [PubMed]
- Ortiz, R.; Koh, D.; Kim, D.H.; Rabbani, M.T.; Velasquez, C.A.; Sonker, M.; Arriaga, E.A.; Ros, A. Continuous Organelle Separation in an Insulator-based Dielectrophoretic Device. Electrophoresis 2022, 43, 1283–1296. [Google Scholar] [CrossRef] [PubMed]
- Chen, H.; Yamakawa, T.; Inaba, M.; Nakano, M.; Suehiro, J. Characterization of Extra-Cellular Vesicle Dielectrophoresis and Estimation of Its Electric Properties. Sensors 2022, 22, 3279. [Google Scholar] [CrossRef]
- Ayala-Mar, S.; Gallo-Villanueva, R.C.; González-Valdez, J. Dielectrophoretic Manipulation of Exosomes in a Multi-Section Microfluidic Device. Mater. Today Proc. 2019, 13, 332–340. [Google Scholar] [CrossRef]
- Lan, M.; Ren, Z.; Cheng, C.; Li, G.; Yang, F. Small Extracellular Vesicles Detection Using Dielectrophoresis-Based Microfluidic Chip for Diagnosis of Breast Cancer. Biosens. Bioelectron. 2024, 259, 116382. [Google Scholar] [CrossRef]
- Río, J.S.d.; Son, Y.; Park, J.; Sunkara, V.; Cho, Y.-K. Microfluidic Dielectrophoretic Purification of Extracellular Vesicles from Plasma Lipoproteins. Langmuir 2024, 40, 25772–25784. [Google Scholar] [CrossRef]
- Sano, M.B.; Henslee, E.A.; Schmelz, E.; Davalos, R.V. Contactless Dielectrophoretic Spectroscopy: Examination of the Dielectric Properties of Cells Found in Blood. Electrophoresis 2011, 32, 3164–3171. [Google Scholar] [CrossRef]
- Chen, C.-C.; Lin, P.-H.; Chung, C.-K. Microfluidic Chip for Plasma Separation from Undiluted Human Whole Blood Samples Using Low Voltage Contactless Dielectrophoresis and Capillary Force. Lab Chip 2014, 14, 1996–2001. [Google Scholar] [CrossRef]
- Sano, M.B.; Caldwell, J.L.; Davalos, R.V. Modeling and Development of a Low Frequency Contactless Dielectrophoresis (CDEP) Platform to Sort Cancer Cells from Dilute Whole Blood Samples. Biosens. Bioelectron. 2011, 30, 13–20. [Google Scholar] [CrossRef] [PubMed]
- Hoettges, K.F.; Henslee, E.A.; Serrano, R.M.T.; Jabr, R.I.; Abdallat, R.G.; Beale, A.D.; Waheed, A.; Camelliti, P.; Fry, C.H.; van der Veen, D.R.; et al. Ten–Second Electrophysiology: Evaluation of the 3DEP Platform for High-Speed, High-Accuracy Cell Analysis. Sci. Rep. 2019, 9, 19153. [Google Scholar] [CrossRef] [PubMed]
- Hughes, M.P.; Kruchek, E.J.; Beale, A.D.; Kitcatt, S.J.; Qureshi, S.; Trott, Z.P.; Charbonnel, O.; Agbaje, P.A.; Henslee, E.A.; Dorey, R.A.; et al. Vm-Related Extracellular Potentials Observed in Red Blood Cells. Sci. Rep. 2021, 11, 19446. [Google Scholar] [CrossRef] [PubMed]
- Faraghat, S.A.; Hoettges, K.F.; Steinbach, M.K.; Veen, D.R.v.d.; Brackenbury, W.J.; Henslee, E.A.; Labeed, F.H.; Hughes, M.P. High-Throughput, Low-Loss, Low-Cost, and Label-Free Cell Separation Using Electrophysiology-Activated Cell Enrichment. Proc. Natl. Acad. Sci. USA 2017, 114, 4591–4596. [Google Scholar] [CrossRef] [PubMed]
- Ding, J.; Lawrence, R.M.; Jones, P.V.; Hogue, B.G.; Hayes, M.A. Concentration of Sindbis Virus with Optimized Gradient Insulator-Based Dielectrophoresis. Analyst 2016, 141, 1997–2008. [Google Scholar] [CrossRef]
- Ware, J.; Shea, D.; Lim, J.Y.; Malakian, A.; Armstrong, R.; Pethig, R.; Ibsen, S. Collection of Serum Albumin Aggregate Nanoparticles from Human Plasma by Dielectrophoresis. Electrophoresis 2024, 45, 1748–1763. [Google Scholar] [CrossRef] [PubMed]
- Ware, J.P.; Shea, D.K.; Nicholas, S.L.; Stimson, E.A.; Riesterer, J.L.; Ibsen, S.D. Recovery and Analysis of Bacterial Membrane Vesicle Nanoparticles from Human Plasma Using Dielectrophoresis. Biosensors 2024, 14, 456. [Google Scholar] [CrossRef] [PubMed]
- Pethig, R. Review—Where Is Dielectrophoresis (DEP) Going? J. Electrochem. Soc. 2017, 164, B3049–B3055. [Google Scholar] [CrossRef]
- Shafiee, H.; Caldwell, J.L.; Sano, M.B.; Davalos, R.V. Contactless Dielectrophoresis: A New Technique for Cell Manipulation. Biomed. Microdevices 2009, 11, 997–1006. [Google Scholar] [CrossRef]
- Rahmani, A.; Mohammadi, A.; Kalhor, H.R. A Continuous Flow Microfluidic Device Based on Contactless Dielectrophoresis for Bioparticles Enrichment. Electrophoresis 2018, 39, 445–455. [Google Scholar] [CrossRef] [PubMed]
- Gwon, H.R.; Chang, S.T.; Choi, C.K.; Jung, J.; Kim, J.; Lee, S.H. Development of a New Contactless Dielectrophoresis System for Active Particle Manipulation Using Movable Liquid Electrodes. Electrophoresis 2014, 35, 2014–2021. [Google Scholar] [CrossRef] [PubMed]
- Davalos, R.V.; Shafiee, H.; Sano, M.B.; Caldwell, J.L. Devices and Methods for Contactless Dielectrophoresis for Cell or Particle Manipulation. U.S. Patent 11,519,877, 6 December 2022. [Google Scholar]
- Sano, M.B.; Salmanzadeh, A.; Davalos, R.V. Multilayer Contactless Dielectrophoresis: Theoretical Considerations. Electrophoresis 2012, 33, 1938–1946. [Google Scholar] [CrossRef] [PubMed]
- David, F.; Hebeisen, M.; Schade, G.; Franco-Lara, E.; Berardino, M.D. Viability and Membrane Potential Analysis of Bacillus Megaterium Cells by Impedance Flow Cytometry. Biotechnol. Bioeng. 2012, 109, 483–492. [Google Scholar] [CrossRef] [PubMed]
- Maalouf, R.; Fournier-Wirth, C.; Coste, J.; Chebib, H.; Saïkali, Y.; Vittori, O.; Errachid, A.; Cloarec, J.-P.; Martelet, C.; Jaffrezic-Renault, N. Label-Free Detection of Bacteria by Electrochemical Impedance Spectroscopy: Comparison to Surface Plasmon Resonance. Anal. Chem. 2007, 79, 4879–4886. [Google Scholar] [CrossRef] [PubMed]
- Clausen, C.H.; Dimaki, M.; Bertelsen, C.V.; Skands, G.E.; Rodriguez-Trujillo, R.; Thomsen, J.D.; Svendsen, W.E. Bacteria Detection and Differentiation Using Impedance Flow Cytometry. Sensors 2018, 18, 3496. [Google Scholar] [CrossRef]
- Conteduca, D.; Brunetti, G.; Dell’Olio, F.; Armenise, M.N.; Krauss, T.F.; Ciminelli, C. Monitoring of Individual Bacteria Using Electro-Photonic Traps. Biomed. Opt. Express 2019, 10, 3463. [Google Scholar] [CrossRef]
- Ohlsson, P.; Petersson, K.; Augustsson, P.; Laurell, T. Acoustic Impedance Matched Buffers Enable Separation of Bacteria from Blood Cells at High Cell Concentrations. Sci. Rep. 2018, 8, 9156. [Google Scholar] [CrossRef] [PubMed]
- Salam, F.; Uludag, Y.; Tothill, I.E. Real-Time and Sensitive Detection of Salmonella Typhimurium Using an Automated Quartz Crystal Microbalance (QCM) Instrument with Nanoparticles Amplification. Talanta 2013, 115, 761–767. [Google Scholar] [CrossRef]
- Huang, L.R.; Cox, E.C.; Austin, R.H.; Sturm, J.C. Continuous Particle Separation Through Deterministic Lateral Displacement. Science 2004, 304, 987–990. [Google Scholar] [CrossRef] [PubMed]
- Cabodi, M.; Chen, Y.-F.; Turner, S.W.P.; Craighead, H.G.; Austin, R.H. Continuous Separation of Biomolecules by the Laterally Asymmetric Diffusion Array with Out-of-Plane Sample Injection. Electrophoresis 2002, 23, 3496–3503. [Google Scholar] [CrossRef] [PubMed]
- McGrath, J.; Jimenez, M.; Bridle, H. Deterministic Lateral Displacement for Particle Separation: A Review. Lab Chip 2014, 14, 4139–4158. [Google Scholar] [CrossRef] [PubMed]
- Loutherback, K.; D’Silva, J.; Liu, L.; Wu, A.; Austin, R.H.; Sturm, J.C. Deterministic Separation of Cancer Cells from Blood at 10 ML/Min. AIP Adv. 2012, 2, 042107. [Google Scholar] [CrossRef]
- Aghaamoo, M.; Aghilinejad, A.; Chen, X.; Xu, J. On the Design of Deterministic Dielectrophoresis for Continuous Separation of Circulating Tumor Cells from Peripheral Blood Cells. Electrophoresis 2019, 40, 1486–1493. [Google Scholar] [CrossRef] [PubMed]
- Quek, R.; Le, D.V.; Chiam, K.-H. Separation of Deformable Particles in Deterministic Lateral Displacement Devices. Phys. Rev. E 2011, 83, 056301. [Google Scholar] [CrossRef]
- Bonten, M.; Johnson, J.R.; Biggelaar, A.H.J.v.d.; Georgalis, L.; Geurtsen, J.; de Palacios, P.I.; Gravenstein, S.; Verstraeten, T.; Hermans, P.; Poolman, J.T. Epidemiology of Escherichia coli Bacteremia: A Systematic Literature Review. Clin. Infect. Dis. 2020, 72, 1211–1219. [Google Scholar] [CrossRef]
- Daga, A.P.; Koga, V.L.; Soncini, J.G.M.; Matos, C.M.d.; Perugini, M.R.E.; Pelisson, M.; Kobayashi, R.K.T.; Vespero, E.C. Escherichia coli Bloodstream Infections in Patients at a University Hospital: Virulence Factors and Clinical Characteristics. Front. Cell. Infect. Microbiol. 2019, 9, 191. [Google Scholar] [CrossRef]
- Giannella, M.; Pascale, R.; Toschi, A.; Ferraro, G.; Graziano, E.; Furii, F.; Bartoletti, M.; Tedeschi, S.; Ambretti, S.; Lewis, R.E.; et al. Treatment Duration for Escherichia coli Bloodstream Infection and Outcomes: Retrospective Single-Centre Study. Clin. Microbiol. Infect. 2018, 24, 1077–1083. [Google Scholar] [CrossRef]
- Vihta, K.-D.; Stoesser, N.; Llewelyn, M.J.; Quan, T.P.; Davies, T.; Fawcett, N.J.; Dunn, L.; Jeffery, K.; Butler, C.C.; Hayward, G.; et al. Trends over Time in Escherichia coli Bloodstream Infections, Urinary Tract Infections, and Antibiotic Susceptibilities in Oxfordshire, UK, 1998–2016: A Study of Electronic Health Records. Lancet Infect. Dis. 2018, 18, 1138–1149. [Google Scholar] [CrossRef] [PubMed]
- Lamy, B.; Sundqvist, M.; Idelevich, E.A. Endocarditis and Sepsis Bloodstream Infections—Standard and Progress in Pathogen Diagnostics. Clin. Microbiol. Infect. 2020, 26, 142–150. [Google Scholar] [CrossRef] [PubMed]
- Hernandez-Pastor, L.; Geurtsen, J.; Baugh, B.; Khoury, A.C.E.; Kalu, N.; Gauthier-Loiselle, M.; Bungay, R.; Cloutier, M.; Sarnecki, M.; Saade, E. Clinical Burden of Invasive Escherichia coli Disease among Older Adult Patients Treated in Hospitals in the United States. BMC Infect. Dis. 2023, 23, 550. [Google Scholar] [CrossRef]
- Akbar, A.; Naeem, W.; Liaqat, F.; Sadiq, M.B.; Shafee, M.; Gul, Z.; Khan, S.A.; Mengal, H.; Chein, S.H.; Qasim, S.; et al. Hospital Acquired Pathogenic Escherichia coli from Clinical and Hospital Water Samples of Quetta Balochistan. J. Trop. Med. 2022, 2022, 6495044. [Google Scholar] [CrossRef] [PubMed]
- Wu, B.; Qi, C.; Wang, L.; Yang, W.; Zhou, D.; Wang, M.; Dong, Y.; Weng, H.; Li, C.; Hou, X.; et al. Detection of Microbial Aerosols in Hospital Wards and Molecular Identification and Dissemination of Drug Resistance of Escherichia coli. Environ. Int. 2020, 137, 105479. [Google Scholar] [CrossRef] [PubMed]
- MacKinnon, M.C.; McEwen, S.A.; Pearl, D.L.; Lyytikäinen, O.; Jacobsson, G.; Collignon, P.; Gregson, D.B.; Valiquette, L.; Laupland, K.B. Mortality in Escherichia coli Bloodstream Infections: A Multinational Population-Based Cohort Study. BMC Infect. Dis. 2021, 21, 606. [Google Scholar] [CrossRef] [PubMed]
- Salam, M.A.; Al-Amin, M.Y.; Salam, M.T.; Pawar, J.S.; Akhter, N.; Rabaan, A.A.; Alqumber, M.A.A. Antimicrobial Resistance: A Growing Serious Threat for Global Public Health. Healthcare 2023, 11, 1946. [Google Scholar] [CrossRef] [PubMed]
- Wong, C. Antibiotic Resistance Is a Growing Threat—Is Climate Change Making It Worse? Nature 2024. [Google Scholar] [CrossRef]
- Ahmed, S.K.; Hussein, S.; Qurbani, K.; Ibrahim, R.H.; Fareeq, A.; Mahmood, K.A.; Mohamed, M.G. Antimicrobial Resistance: Impacts, Challenges, and Future Prospects. J. Med. Surg. Public. Health 2024, 2, 100081. [Google Scholar] [CrossRef]
- Amarsy, R.; Trystram, D.; Cambau, E.; Monteil, C.; Fournier, S.; Oliary, J.; Junot, H.; Sabatier, P.; Porcher, R.; Robert, J.; et al. Surging Bloodstream Infections and Antimicrobial Resistance during the First Wave of COVID–19: A Study in a Large Multihospital Institution in the Paris Region. Int. J. Infect. Dis. 2022, 114, 90–96. [Google Scholar] [CrossRef]
- Douglas, T.A.; Cemazar, J.; Balani, N.; Sweeney, D.C.; Schmelz, E.M.; Davalos, R.V. A Feasibility Study for Enrichment of Highly Aggressive Cancer Subpopulations by Their Biophysical Properties via Dielectrophoresis Enhanced with Synergistic Fluid Flow. Electrophoresis 2017, 38, 1507–1514. [Google Scholar] [CrossRef] [PubMed]
- Cemazar, J.; Douglas, T.A.; Schmelz, E.M.; Davalos, R.V. Enhanced Contactless Dielectrophoresis Enrichment and Isolation Platform via Cell-Scale Microstructures. Biomicrofluidics 2016, 10, 14109. [Google Scholar] [CrossRef] [PubMed]
- Adams, T.N.G.; Jiang, A.Y.L.; Mendoza, N.S.; Ro, C.C.; Lee, D.-H.; Lee, A.P.; Flanagan, L.A. Label-Free Enrichment of Fate-Biased Human Neural Stem and Progenitor Cells. Biosens. Bioelectron. 2020, 152, 111982. [Google Scholar] [CrossRef] [PubMed]
- Hyler, A.R.; Hong, D.; Davalos, R.V.; Swami, N.S.; Schmelz, E.M. A Novel Ultralow Conductivity Electromanipulation Buffer Improves Cell Viability and Enhances Dielectrophoretic Consistency. Electrophoresis 2021, 42, 1366–1377. [Google Scholar] [CrossRef] [PubMed]
- Farmehini, V.; Rohani, A.; Su, Y.-H.; Swami, N.S. A Wide-Bandwidth Power Amplifier for Frequency-Selective Insulator-Based Dielectrophoresis. Lab Chip 2014, 14, 4183–4187. [Google Scholar] [CrossRef]
- Swami, N.S.; Rohani, A.; Farmehini, V.; Varhue, W. Amplifier System and Controls for Dielectrophoretic Tracking in Microfluidic Devices. U.S. Patent 11,339,417, 24 May 2022. [Google Scholar]
- Jumutc, V.; Suponenkovs, A.; Bondarenko, A.; Bļizņuks, D.; Lihachev, A. Hybrid Approach to Colony-Forming Unit Counting Problem Using Multi-Loss U-Net Reformulation. Sensors 2023, 23, 8337. [Google Scholar] [CrossRef] [PubMed]
- Opota, O.; Croxatto, A.; Prod’hom, G.; Greub, G. Blood Culture-Based Diagnosis of Bacteraemia: State of the Art. Clin. Microbiol. Infect. 2015, 21, 313–322. [Google Scholar] [CrossRef] [PubMed]
Disclaimer/Publisher’s Note: The statements, opinions and data contained in all publications are solely those of the individual author(s) and contributor(s) and not of MDPI and/or the editor(s). MDPI and/or the editor(s) disclaim responsibility for any injury to people or property resulting from any ideas, methods, instructions or products referred to in the content. |
© 2025 by the authors. Licensee MDPI, Basel, Switzerland. This article is an open access article distributed under the terms and conditions of the Creative Commons Attribution (CC BY) license (https://creativecommons.org/licenses/by/4.0/).